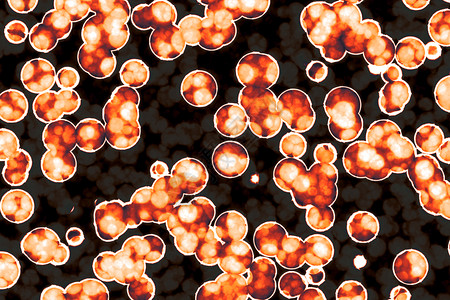
埃博拉病毒细菌胞的形状共生菌bacilli菌螺旋本底背景

bacilli

gram positive bacilli and related organisms
图片尺寸500x331
细菌胞的形状共生菌bacilli菌螺旋本底图片素材
图片尺寸450x300
细菌胞的形状共角bacilli图片
图片尺寸450x300
细菌胞的形状共生菌bacilli菌螺旋本底图片素材
图片尺寸450x300
细菌胞的形状共生菌bacilli菌螺旋本底图片素材
图片尺寸450x300
基础医学 第7章 肠杆菌科ppt 肠杆菌科 肠道杆菌(enteric bacilli)
图片尺寸1080x810
杆菌;芽孢杆菌;细菌 [ 复数 bacilli
图片尺寸700x481
细菌胞的形状共生菌bacilli菌螺旋本底图片素材
图片尺寸450x300
一些大肠杆菌的图片
图片尺寸505x539
预订 bacilli in agrobiotechnology
图片尺寸330x499
细菌胞的形状共角bacilli图片
图片尺寸450x300
【4周达】carbapenem resistant gram-negative bacilli: a real life
图片尺寸800x800
埃博拉病毒细菌胞的形状共生菌bacilli菌螺旋本底背景
图片尺寸450x300
埃博拉病毒细菌胞的形状共生菌bacilli菌螺旋本底背景
图片尺寸450x300
结核分枝杆菌(m. tuberculosis)简称为结核杆菌(tubercle bacilli).
图片尺寸668x553
细菌胞的形状共生菌bacilli菌螺旋本底图片素材
图片尺寸450x300
微生物寄生虫学
图片尺寸642x802
埃博拉病毒细菌胞的形状共生菌bacilli菌螺旋本底背景
图片尺寸450x300
插图素材: 精力充沛的bacilli兄弟手绘插图
图片尺寸450x468
【预订】a comparative and experimental study of bacilli
图片尺寸500x500